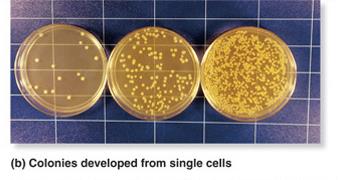
Bacterial colonies from single cells

Back
BackBacteria and Archaea: Diversity, Structure, and Ecological Roles
Study Guide - Smart Notes

Bacteria and Archaea
Overview of the Three Domains of Life
The three domains of life—Bacteria, Archaea, and Eukarya—represent fundamental divisions in biological classification. Bacteria and Archaea are both prokaryotic, meaning they lack a membrane-bound nucleus, but they differ significantly in their molecular and structural characteristics. Eukarya includes all organisms with a true nucleus, such as plants, animals, fungi, and protists.
Bacteria: Prokaryotic, unicellular, diverse in metabolism and structure.
Archaea: Prokaryotic, unicellular, often extremophiles, share some features with Eukarya.
Eukarya: Eukaryotic, unicellular or multicellular, membrane-bound organelles.
Evolutionary Relationships: Archaea are more closely related to Eukarya than to Bacteria.


Major Groups and Diversity
Bacteria and Archaea are divided into numerous phyla, each with unique characteristics. Horizontal gene transfer is common among prokaryotes, contributing to their genetic diversity and evolutionary adaptability.
Proteobacteria, Cyanobacteria, Firmicutes, Actinobacteria (Bacteria)
Crenarchaeota, Euryarchaeota, Thaumarchaeota (Archaea)
Horizontal Gene Transfer: Movement of genes between species, increasing diversity.

Domain Archaea
Unique Features and Extremophiles
Archaea possess several features in common with Eukarya, such as histones and certain aspects of their cell structure. Many archaea are extremophiles, thriving in environments with extreme temperature, salinity, or acidity.
Membrane Linkages: Ether bonds in phospholipids, more resistant to heat and extremes.
Extremophiles: Halophiles (salt-loving), thermophiles (heat-loving), acidophiles (acid-loving).
Examples: Archaea found in hot springs, salt lakes, deep-sea vents.



Domain Bacteria
Diversity and Ecological Roles
Bacteria are highly diverse, with over 50 phyla. While some are extremophiles, most bacteria prefer moderate environments and often form symbiotic relationships with eukaryotes.
Cyanobacteria: Photosynthetic, abundant in aquatic environments, generate oxygen.
Structural Diversity: Unicellular, colonial, or filamentous forms.
Ecological Roles: Producers of organic carbon, nitrogen fixers, decomposers.



Horizontal Gene Transfer
Mechanisms and Evolutionary Importance
Horizontal gene transfer (HGT) is the movement of genetic material between organisms other than by descent. It is widespread in prokaryotes and has played a crucial role in the evolution of metabolic pathways and the origin of eukaryotic organelles.
Mechanisms: Transformation (uptake of DNA), Transduction (viral transfer), Conjugation (cell-to-cell transfer).
Evolutionary Impact: Transfer of photosynthesis genes from cyanobacteria to eukaryotes, origin of mitochondria and plastids via endosymbiosis.

Structure and Motility
Cell Size, Shape, and Arrangement
Bacteria and Archaea are typically small (1–5 μm), allowing rapid growth and reproduction. They exhibit a variety of shapes and arrangements, which are important for identification and ecological function.
Shapes: Cocci (spheres), Bacilli (rods), Vibrios (comma-shaped), Spirochaetes (flexible spirals), Spirilli (rigid spirals).
Arrangements: Single cells, pairs, filaments, colonies.




Cell Wall Structure
Most prokaryotes have a rigid cell wall outside the plasma membrane, which maintains cell shape and protects against environmental stress. The composition of the cell wall is a key factor in bacterial classification.
Gram-positive: Thick peptidoglycan layer, stains purple, sensitive to penicillin.
Gram-negative: Thin peptidoglycan layer, outer lipid membrane, resistant to penicillin.


Reproduction and Genetic Exchange
Binary Fission and Genetic Material Acquisition
Prokaryotes reproduce primarily by binary fission, a process in which a cell divides into two identical daughter cells. Genetic diversity is enhanced by several mechanisms of gene transfer.
Binary Fission: Simple cell division, rapid population growth.
Transduction: DNA transfer via viruses.
Transformation: Uptake of DNA from the environment.
Conjugation: Direct transfer of DNA between cells.
Nutrition and Metabolism
Classification by Nutrition and Oxygen Response
Bacteria and Archaea exhibit the most diverse metabolic strategies of any group of organisms. They are classified based on their energy and carbon sources, as well as their response to oxygen.
Photoautotrophs: Use light for energy and CO2 for carbon.
Photoheterotrophs: Use light for energy, organic compounds for carbon.
Chemoautotrophs: Use inorganic chemicals for energy, CO2 for carbon.
Chemoheterotrophs: Use organic compounds for both energy and carbon.
Oxygen Response: Obligate aerobes (require O2), facultative aerobes (can use O2 or not), obligate anaerobes (cannot tolerate O2), aerotolerant anaerobes (do not use O2 but are not poisoned by it).
Ecological Roles
Carbon and Nitrogen Cycles
Prokaryotes play essential roles in global biogeochemical cycles, including the carbon and nitrogen cycles. They act as producers, decomposers, and nitrogen fixers, facilitating nutrient recycling and supporting ecosystem productivity.
Producers: Synthesize organic compounds used by other organisms.
Decomposers: Break down dead organisms, releasing minerals.
Methanogens: Produce methane.
Methanotrophs: Consume methane.
Nitrogen Fixation: Conversion of atmospheric N2 to biologically usable forms.
Symbiotic Roles
Types of Symbiosis
Prokaryotes engage in various symbiotic relationships with other organisms, including mutualism, commensalism, and parasitism. These interactions are crucial for the health and functioning of many ecosystems and host organisms.
Mutualism: Both partners benefit (e.g., gut bacteria in humans).
Commensalism: One partner benefits, the other is unaffected.
Parasitism: One partner benefits at the expense of the other; pathogens cause disease.
Human Microbiome: Bacteria on skin and in digestive/reproductive systems provide essential services.
Examples: Bioluminescent bacteria in squid, bacteria-induced development in algae, pathogenic bacteria causing diseases.
Key Terms and Definitions
Halophile: Organism that thrives in high salt concentrations.
Extremophile: Organism that lives in extreme environmental conditions.
Thermophile: Organism that thrives at high temperatures.
Methanogen: Microbe that produces methane as a metabolic byproduct.
Decomposer: Organism that breaks down dead material.
Nitrogen Fixation: Conversion of atmospheric nitrogen to ammonia.
Aerobic: Requires oxygen.
Anaerobic: Does not require oxygen.
Photoautotroph: Uses light and CO2 for energy and carbon.
Photoheterotroph: Uses light for energy, organic compounds for carbon.
Chemoautotroph: Uses inorganic chemicals for energy, CO2 for carbon.
Chemoheterotroph: Uses organic compounds for energy and carbon.
Transformation: Uptake of DNA from the environment.
Transduction: DNA transfer via viral vector.
Conjugation: Direct transfer of DNA between cells.
Mutualism: Both partners benefit.
Commensalism: One benefits, other unaffected.
Parasitism: One benefits at other's expense.
----------------------------------------
